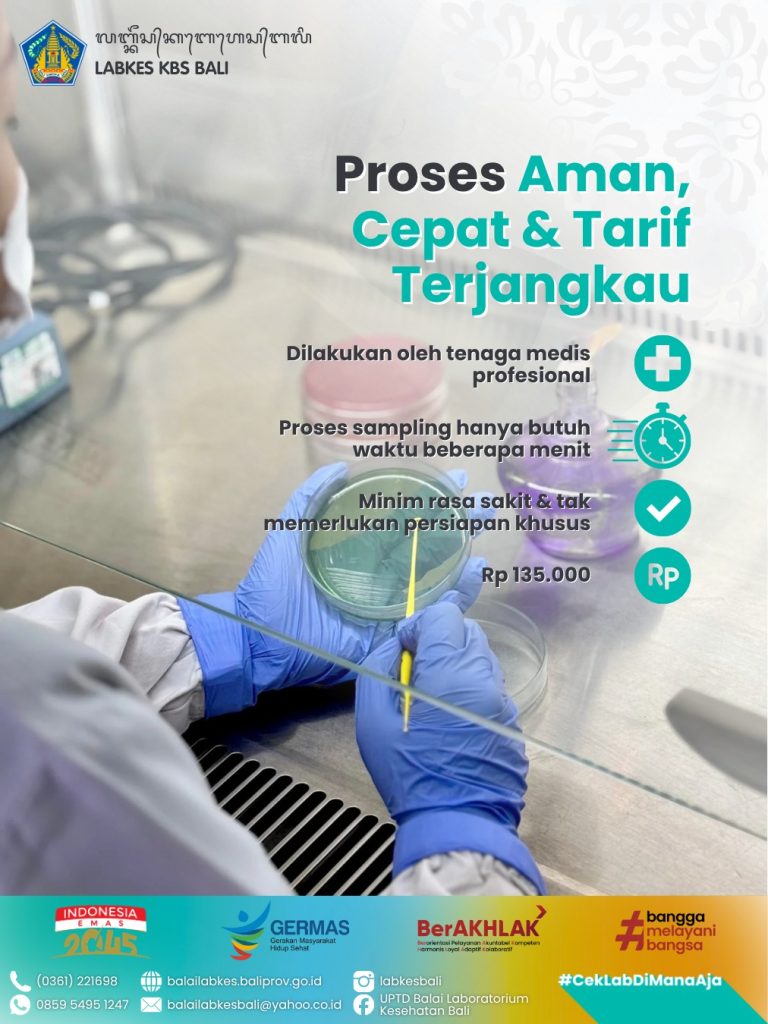

Sering mengalami gangguan pencernaan atau butuh syarat sertifikasi penjamah makanan (food handler)? Rectal Swab adalah solusinya. 🔬✨
Pemeriksaan ini bertujuan untuk mendeteksi bakteri patogen dalam saluran pencernaan secara akurat, cepat, dan efektif. Langkah kecil ini sangat penting untuk memastikan kesehatan pribadi serta keamanan pangan bagi sekitar. 🛡️🍽️
Jangan abaikan kesehatan pencernaan Anda. Deteksi dini sekarang jauh lebih baik daripada mengobati kemudian.
𝗟𝗮𝘆𝗮𝗻𝗮𝗻 𝗥𝗲𝗰𝘁𝗮𝗹 𝗦𝘄𝗮𝗯 𝗟𝗮𝗯𝗸𝗲𝘀 𝗞𝗕𝗦 🏥
Hanya dengan 𝗥𝗽𝟭𝟯𝟱.𝟬𝟬𝟬, Anda sudah mendapatkan hasil pemeriksaan laboratorium yang terpercaya.
Silakan hubungi kami untuk informasi lebih lanjut:
🟢 WhatsApp: 0859 5495 1247
📞 Telepon: (0361) 221698